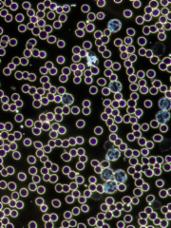

Prices 4 Balance and Health
Card payment
facility
available
although we do not accept American Express
COLONIC IRRIGATION
Colonic Hydrotherapy helps your immune system to help itself, by giving it a chance to breathe and allowing the lymph system to effectively cleanse the body. It is extremely safe, and only takes up to a maximum of 45 minutes.
Single treatment:
Closed system (The Aqua) 90 mins ......................................... £120 (consultation included)
Open system (The Angel of water) 90 mins ......................................... £120 (consultation included)
Colonic + Enema 90 mins ......................................... £135 (consultation included)
Colonic Follow-up 60 mins ............................................ £100
Colonic + Enema Follow-up 60 mins ............................................ £115
(24hrs notice is required for Coffee enema)Click here for more info on the available systems
COLONIC PACKAGES
(NOT sharable)
These following packages are mainly related around the most common situations that people go throughout life. Starting from constipation, detox program, a quick start to a healthier living or even maintenance. If you have a specific need for an enema treatment, go to the enema menu for more info. You can decide if you would like an enema added to the colonic treatment or prefer an enema only.
Constipation:Severe constipation is caused by many different factors from a stressful lifestyle, eating processed foods, a lack of fibre and water in our diet, or even ignoring the call of nature too often and not doing enough exercise. Iron supplementation and the use of some medication such as narcotic-type, pain-killers including codeine, and some other medicines used to control blood pressure, are also known to cause constipation. Colonic Hydrotherapy is a great tool for helping along some blockages that one might experience.I recommend an intensive course of 3 treatments for a 14 days period
for better result before considering a maintenance program.Detoxifying:The reason why it is so important for both men and women to control their weight is because you must know that toxins are stored in our fat cells. Yes, that's right, fats store toxins! Weight gain produces toxins, and toxins get stored in our fats cells. The more toxins produced, the more room is needed to store additional toxins, and indeed you can see that viscious circle of weight increase. Even if our body has got its own detoxifying mechanism, toxins cannot always be expelled by the body therefore these toxins get stored in the liver, kidneys, lungs, joints, pancreas and in fat tissue bringing the body to an inflammatory state.
This is a fantastic package in helping any detoxifying or weight loss program that you might have taken on. You will be able to use these 3 to 6 colonics to help in the elimination process of those unwanted toxins throughout the detoxifying process. Ironically, Detoxifying is by itself a very toxic process!
Validity Colonics with Closed system
(the Aqua)Colonics with Open system
(Angel of water)Mixed colonics
(open and closed system
or/and with added enema)Quantity 6 months £270 £270 £300 3 12 months £500 £500 £600 6
ENEMAS
(24hrs notice is required for Coffee enema)
I do not recommend Enemas alone if there is a long standing constipation issue as it might not have a deep enough effect. I would strongly recommend that you try a colonic irrigation instead. If you have a daily bowel movement and you want to boost up hydration or enhance your gut's health, then we can discuss which enema would be most appropriate for you to have.
Enema: (single treatment)
Coffee ................................................ £85
Probiotics ................................................. £85
Wheatgrass ................................................. £85Click here for more info on EnemasENEMA PACKAGES
(NOT sharable)
X 3 Enemas £240 3 months validity X 4 Enemas £300 4 months validity X 12 Enemas £800 12 months validity
5 ELEMENTS AROMAFLEXOLOGY
Both Essentail oil and Reflexology therapy are preventative and soothing healing arts.
Combined together, their goal is to return your body and mind to a state of equilibrium, when too much stress has created imbalances.
![]()
|
BLOOD TYPE TESTING: ................................................................. £50
90 mins LIVE BLOOD ANALYSIS only: .......................................... £215
60 mins LIVE BLOOD ANALYSIS Follow-up ................................. £17590 mins LIVE AND DRY BLOOD ANALYSIS ................................. £295 (Dry Blood report back within a week)
60 mins LDBA Follow-up ................................................................ £255 (Dry Blood report back within a week)This 90 minutes LBA consultation will give you a glimpse into the world of your blood. I will put a drop of your blood onto a slide and place it under the microscope. This will be a great opportunity to view the current state and quality of your blood.
What should you expect from a Live Blood Analysis viewing?
I will give you a basic description of the different blood cells encountered in your sample. I will show you a healthy blood picture before we can start viewing yours. This will give you an opportunity to gain an understanding of what you can aim for as to improve certain areas of your health. This viewing is also a fantastic tool for witnessing your blood's behaviour throughout your present lifestyle as it will bring forward imbalances you might be going through at this particular time.What should you expect from a DRY Blood Analysis viewing?
Another drop of your blood will be taken right after the one I took and used for your Live Blood Analysis viewing. This blood drop will need a couple of hours to dry and therefore doesn't get viewed and analysed on your appointment day. Once your drop of blood has dried, I will then analyse it and send you the report within 1 week. This viewing is complementary to the Live Blood viewing as to validate what has been detected in the Live Blood Analysis but first and foremost, the Dry blood viewing gives the severity of oxidative stress within the body.For your Live and Dry Blood Analysis viewing,please avoid eating or drinking for 5 hours before your treatment, except water.Click here for more info on Live Blood Analysis
![]() |
1 hour consultation:..........£120
(The hour consultation fee goes toward the package purchased)
3 Day Package ............... £550
- 3 Day Waning fasting plan
- Blood Type Testing with compatibility food chart
- 2 Colonics
- 1 Colonic with coffee enema
- 1 coffee enema
5 Day Package ............... £750
- 5 Day Waning fasting plan
- Blood Type Testing with compatibility food chart
- 2 Colonics
- 1 Colonic with coffee enema
- 1 coffee enema
- 2 Aromaflexology Treatments
7 Day Package ............... £1295
- 7 Day Waning fasting plan
- Blood Type Testing with compatibility food chart
- 2 Colonics
- 1 Colonic with coffee enema
- 1 coffee enema
- 2 Aromaflexology treatments
- 2 Mind coaching sessions with Cognitive Hypnotherapy
- 1 Live Blood Analysis viewing (choice of before or after the Detox)
- A mystery free gift
I will be happy to answer any enquiries you might have.
Therapies offered at 4 Balance and Health are not substitutes for traditional medical care by your GP, they are complementary therapies that may be used in conjunction with conventional medicine. Should you be aware of any reasons why these therapies are contra-indicated to you or you have a serious health problem, please consult your GP prior to their use.